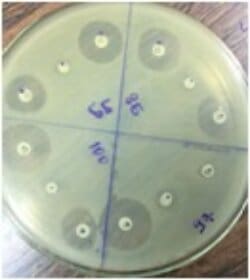

Pesquisa avalia coinfecção de bactérias de ambientes hospitalares e o vírus da Covid-19 em crianças

Desde que foi oficialmente decretada pandemia, no dia 11 de março de 2020, cientistas de todo o mundo têm buscado, nas mais diversas linhas de pesquisas, entender o complexo Sars-CoV-2, suas origens, causas, consequências, prevenção e cura. Investimentos e projetos são apresentados na tentativa de enfrentar a emergência sanitária que o novo coronavírus vem impondo.
Indagações a respeito da possível coinfecção de micro-organismos com a infecção da Covid-19, potencializando a doença, levaram a professora Lilian Carla Carneiro, do Instituto de Patologia Tropical e Saúde Pública (IPTSP), da Universidade Federal de Goiás (UFG) e sua equipe a desenvolverem o projeto “Caracterização da multirresistência de Pseudomonas aeruginosa em coinfecção com Covid-19 e vírus respiratórios em infantis hospitalizados”.

O projeto foi um dos 20 selecionados pela Fundação de Amparo à Pesquisa do Estado de Goiás (Fapeg) por meio da Chamada Pública nº 05/2020 – 7ª Edição do Programa Pesquisa para o SUS: Gestão Compartilhada em Saúde (PPSUS) e será desenvolvido nos próximos dois anos levando em consideração o pouco conhecimento na literatura mundial sobre sintomas e evolução clínica da Covid-19 na população pediátrica e as possíveis bactérias que dificultam o tratamento pela resistência que têm aos antibióticos e acabam agravando o quadro clínico das crianças. A pesquisa receberá investimentos no valor de R$ 149.999,88.
“O fomento da Fapeg para esta proposta possibilitará a investigação científica, viabilizando aos pesquisadores o desenvolvimento de um estudo em que os resultados serão de grande impacto no âmbito epidemiológico e da saúde pública, aumentando a qualidade de vida das pessoas”, comenta Lilian Carneiro.
Pseudomonas aeruginosa
A P. aeruginosa é uma bactéria ambiental gram-negativa presente em praticamente todos os ambientes terrestres e um dos principais patógenos que afetam pacientes hospitalizados, sendo intrinsecamente resistente a uma ampla gama de antibióticos. “É um patógeno humano oportunista capaz de causar vários tipos de infecções agudas e crônicas que ameaçam a vida, sendo um importante patógeno para pacientes imunocomprometidos”, explica a pesquisadora.
Segundo Lilian Carneiro, a P. aeruginosa vem sendo amplamente associada às Infecções Relacionadas à Assistência em Saúde (IRAS), ou mais conhecidas infecções hospitalares, incluindo pneumonia associada à ventilação mecânica – tubos endotraqueais, infecção da corrente sanguínea associada a cateter central, infecção relacionada a cateter urinário, infecções cirúrgicas.
É uma bactéria comumente associada aos serviços de saúde por ser capaz de sobreviver em superfícies bióticas e abióticas como equipamentos médicos. Muitas vezes são resistentes ao método de desinfecção, sendo transmitida de um paciente para outro. Nesse momento de pandemia estudos correlacionando uma coinfecção de Pseudomonas aeruginosa com Sars-Cov2 são muito importantes, destaca a pesquisadora.
A pesquisa
Serão analisadas 450 amostras de sangue, onde será separado o soro, de crianças desde recém-nascidos até 12 anos de idade que passarem pelo serviço de urgência de dois hospitais pediátricos, o Hospital Materno Infantil (HMI), do sistema público e o Hospital da Criança, do sistema privado; além de crianças internadas em cinco diferentes UTIs pediátricas e neonatais: UTI neonatal do Hospital das Clínicas e do Hospital da Criança e UTIs pediátricas do Hospital da Criança, Hospital de Doenças Tropicais (HDT), Hospital de Urgências Governador Otávio Lage de Siqueira (Hugol) e do HMI. A partir dessas amostras será realizada a extração de DNA plasmidial para investigação dos genes de resistência.
A pesquisa propõe identificar P. aeruginosas associadas à coinfecção com o vírus da Covid-19 e com outros vírus respiratórios que integram o painel viral em crianças de UTIs, estudando o perfil de resistência dos isolados frente aos antimicrobianos utilizados na prática clínica. A partir dessas informações, os pesquisadores vão identificar compostos inibidores de P. aeruginosa e avaliar a citotoxicidade desses compostos. “Será realizado o isolamento de cepas bacterianas de P. aeruginosa com perfis de resistência à antimicrobianos β-lactâmicose que estão em um processo de coinfecção com os tipos virais, potencializando a morbidade do paciente pediátrico”, revela Lilian Carneiro.
“O estudo será fundamental para determinar os cuidados clínicos com o paciente e vai contribuir para a vigilância epidemiológica e a pesquisa de formulação de novas terapias para bactérias associadas a vírus do painel viral e ao Sars-Cov-2, que se apresenta neste momento de pandemia”, destaca a pesquisadora.
O projeto vai utilizar uma metodologia computacional para sugerir modelos de fármacos a serem testados por nanopartículas para uso terapêutico de P. aeruginosa associada a vírus epidemiológicos. As amostras serão selecionadas por serem resistentes ao antibiótico gentamicina, fato que se justifica considerando que essa droga está presente no meio MIV (meio de transporte viral), utilizado no momento da coleta das amostras. O estudo vai selecionar bactérias multidroga resistentes e explorando modelos computacionais para padronização de novas drogas que venham ser ativas e capazes de combater o potencial de coinfecção viral – bacteriano.
Reposicionamento de fármacos
Segundo a pesquisadora, a técnica de reposicionamento de fármacos será utilizada para identificar novos compostos inibidores de proteínas relacionadas à resistência P. aeruginosa. “Essa proposta será um avanço no campo terapêutico, considerando a crise pandêmica instalada, na tentativa de combate a um quadro infeccioso que pode ocasionar a morte do paciente, revertendo o quadro para uma melhora clínica e sobrevida do mesmo”, diz a professora.
Metodologias como o reposicionamento de fármacos serão aplicadas com a finalidade de reavaliar a utilização de um determinado fármaco para tratar doenças diferentes daquelas para as quais ele foi desenvolvido. A estratégia de reposicionamento baseia-se na hipótese de que proteínas que compartilham algum tipo de semelhança estrutural (identidade sequencial, estruturas secundarias semelhantes e sítios ativos) também podem compartilhar os mesmos ligantes (compostos).
A tecnologia desenvolvida na pesquisa pode ser estendida à terapia de outros processos infecciosos, os quais não apresentem coinfecção, possibilitando o uso dos fármacos para uma alta escalabilidade de aplicações, destaca Lilian Carneiro.
Além de possibilitar o conhecimento sobre a incidência da Covid-19 e a associação com a bactéria P. aeruginosa na população pediátrica, o estudo contribuirá para traçar um perfil epidemiológico viral de Síndrome Respiratória Aguda Grave (SRAG) associada à infecção bacteriana nas crianças da Capital correlacionando idade, sexo, evolução clínica e desfecho.

PPSUS: Gestão Compartilhada
O Programa Pesquisa para o SUS: Gestão Compartilhada em Saúde (PPSUS) é conduzido, em Goiás, pela Fapeg em parceria com a Secretaria Estadual da Saúde (SES), o Departamento de Ciência e Tecnologia da Secretaria de Ciência, Tecnologia e Insumos Estratégicos do Ministério da Saúde (Decit/SCTIE/MS) e o Conselho Nacional de Desenvolvimento Científico e Tecnológico (CNPq).
É um programa que une a ciência e a pesquisa como formas de colaborar com a melhoria da qualidade de atenção à saúde no Estado de Goiás oferecendo respostas aos principais problemas e carências da população elencados em discussões de oficinas oferecidas previamente. É uma iniciativa de descentralização do fomento à pesquisa que prioriza a gestão compartilhada de ações.
Atuação
No IPTSP, a professora Lilian Carneiro ministra a disciplina Microbiologia Teórica, no módulo bacteriologia teórica para os cursos: Biotecnologia, Biologia e Farmácia -licenciatura e bacharelado; e bacteriologia prática, para os cursos Biomedicina, Ciências Biológicas e Enfermagem. Na pós-graduação ministra as disciplinas: biotecnologia aplicada ao desenvolvimento de kits para detecção de patógenos no PPGBRPH/ IPTSP UFG e a disciplina de seminários no PPGCS/ FM UFG.



